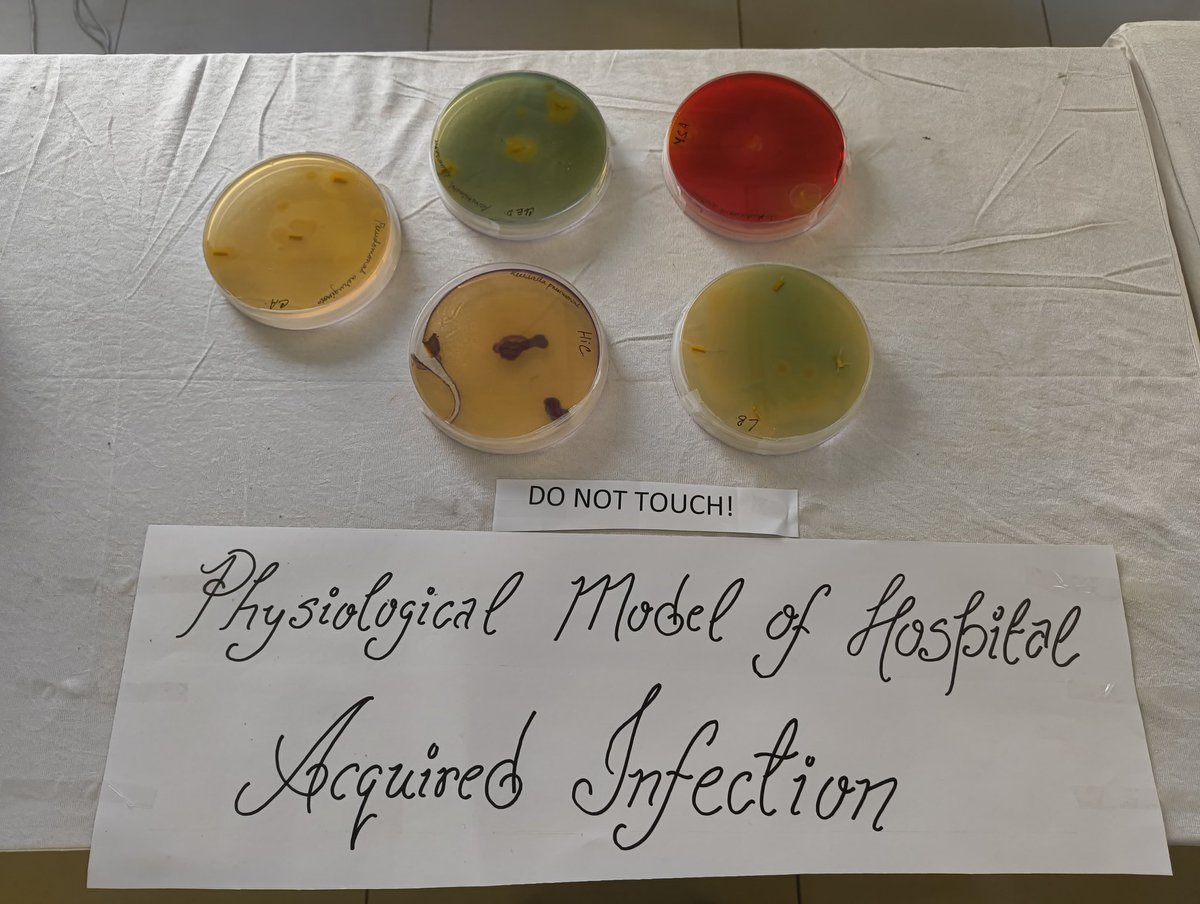

Anmol singh
@anmolsingh82
PhD scholar @DipaLab_IISc, MCB, @iiscbangalore
Quorum sensing and host-pathogen interaction in Salmonella| Antimicrobial resistance| Science enthusiast.
ID: 1561671999843213312
https://mcbl.iisc.ac.in/dclab/ 22-08-2022 11:10:20
54 Tweet
80 Takipçi
250 Takip Edilen

Extremely happy to congratulate Dr. Abhilash Nair and Dr. Dipasree Hajra from my group as they successfully defended their Ph.D Thesis with outstanding work in the field of Salmonella-host interaction. Also thankful to the examiners Prof.Chandrima Saha and Prof.Anirban Banerjee


Happy to share the first publication from my Ph.D thesis in the prestigious journal MicrobiologicalResearch Elsevier on the novel regulation by spermidine in the early stages of Salmonella pathogenesis Prof. Dipshikha Chakravortty's Lab Anmol singh IISc Bangalore authors.elsevier.com/a/1iRVW3MmJPw2…

Hot off the press, kudos to Abhilash Nair for this amazing work on novel regulation during early stages of Salmonella pathogenesis mediated by spermidine, now published in Microbiological Research Elsevier. Thanks to Department of Biotechnology , DSTIndia , DAE India for the funding.


Throwback to GATE-2024 GATE 2024 outreach program from IISc Bangalore to Sambhram Institute . It was great to interact with the faculties and students during the outreach session for GATE24. Debapriya Mukherjee



I am elated to share our recent study published in prestigious journal Redox Biology SFRBM Europe-SFRR Prof. Dipshikha Chakravortty's Lab IISc Bangalore

Happy to share our latest review article on the role of SNAREs in intra-vacuolar bacterial infection; it is one of the featured articles in the current issue of Trends in Microbiology Prof. Dipshikha Chakravortty's Lab, IISc Bangalore cell.com/trends/microbi…


Ecstatic to share our recent research covered by TOI. Finding alternative therapeutics in this devastating age of AMR Prof. Dipshikha Chakravortty's Lab Anmol singh IISc Bangalore The Times Of India SFRBM Elsevier google.com/amp/s/timesofi…

Very interesting piece of work by Abhilash Nair and team. Our research identifies a potential alternative therapeutic strategy to combat the emerging Salmonella AMR Anmol singh IISc Bangalore The Times Of India SFRBM Elsevier google.com/amp/s/timesofi…

IISc Bangalore NEWS covers our recent research . Kudos to the team Abhilash Nair Anmol singh SFRBM Elsevier iisc.ac.in/events/targeti…

Hearty Congratulations to Abhilash Nair on winning the Runner up-II and receiving the prestigious Dr. KV Rao Scientific Society Research Award 2024 for his outstanding work. Well done and always shine ✨✨

Extremely delighted to share our recent publication showing how peroxisomes help in inter-organellar cholesterol transport! Now in EMBO Reports! CSIR-CDRI AcSIR DBT/WT India Alliance Great partnership Veena Ammanathan Prof. Dipshikha Chakravortty's Lab embopress.org/doi/full/10.10…?